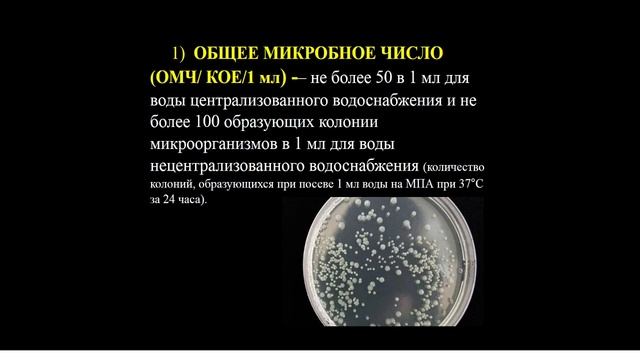
13:20-14:50 Гигиена воды и водоснабжения смотреть онлайн

Автор / Канал: Стройка Вдохновение Страница 13

Аккумулятор для HILTI

Что делать если сверлят соседи

Эргономичное компьютерное кресло для работы от BMA Ergonomics

Aus-8 Versus 420HC

Лазерный станок для гравировки фанеры, лазерный гравер для дерева,гравировальная машина из Китая

"Александрийский портал". Сборка и установка в типа проема №1
13:20-14:50 Гигиена воды и водоснабжения

Billy Graham dans l’émission de Patrick Poivre d' Arvor 1986

Анаэробный клей WEICONLOCK AN 302-70

Чебоксарская фабрика дверей Clariss Doors

МОЙ ОПЫТ. ВЫРАЩИВАЮ АВОКАДО. ПЕРЕСАЖИВАЮ ХУРМУ. ПОСАДИЛА КЛЕМЕНТИНЫ: ГИБРИД МАНДАРИНА И АПЕЛЬСИНА.

Идеальная укладка керамогранита Italon

Как делают угги EMU Australia?

Ювелирные флюсы. РЕЦЕПТЫ и ПРИГОТОВЛЕНИЕ

Герметичная распаячная коробка для закапывания в землю

Нива на чалке

резка пенопласта толщиной 150 мм и более

Делаю кабинет репетитора дома | Ремонт и интерьер домашнего кабинета | Организация кабинета

Стерео микрофон 3.5мм c переходником для GoPro Hero3+, 4 // крутим в руках

Биологические методы борьбы с вредителями

Приставка T2 Supra SD-95 не включается

Servis Pioneer Stereo DVD Tuner Deck XV-IS22DVD Rusak Hidup Sebentar Langsung Mati

MODERN TALKING STYLE | Amadeus Angelus - One Step From Heaven ***Old Home VideoVersion***

РОВНЯЕМ УЧАСТОК ЛОПАТОЙ СВОИМИ РУКАМИ Как Выровнять Участок
За каждым успешным каналом стоит личность, идея и сотни часов кропотливого труда. Если вы здесь, значит, автор «Стройка Вдохновение» уже сумел зацепить ваше внимание своим уникальным стилем или подачей. А мы на RUVIDEO позаботились о том, чтобы вы могли изучить весь архив его работ в максимально комфортных условиях — без лишней суеты и преград.
Почему за работами канала «Стройка Вдохновение» так интересно наблюдать? Всё просто: это честный контент, который находит отклик в сердцах зрителей. На нашем ресурсе вы можете смотреть онлайн все видео любимого автора бесплатно и в хорошем качестве. Нам важно, чтобы вы видели каждую деталь и слышали каждый нюанс, поэтому мы используем только стабильные плееры из открытых источников Rutube.
Следите за новинками канала, пересматривайте старые шедевры и открывайте для себя новые грани творчества «Стройка Вдохновение». Мы постоянно обновляем ленту, чтобы у вас под рукой всегда были самые свежие выпуски. Никаких сложных регистраций — только вы и творчество, которое вдохновляет. Приятного вам путешествия по миру авторского контента на RUVIDEO!
Видео взято из открытых источников Rutube. Если вы правообладатель, обратитесь к первоисточнику.